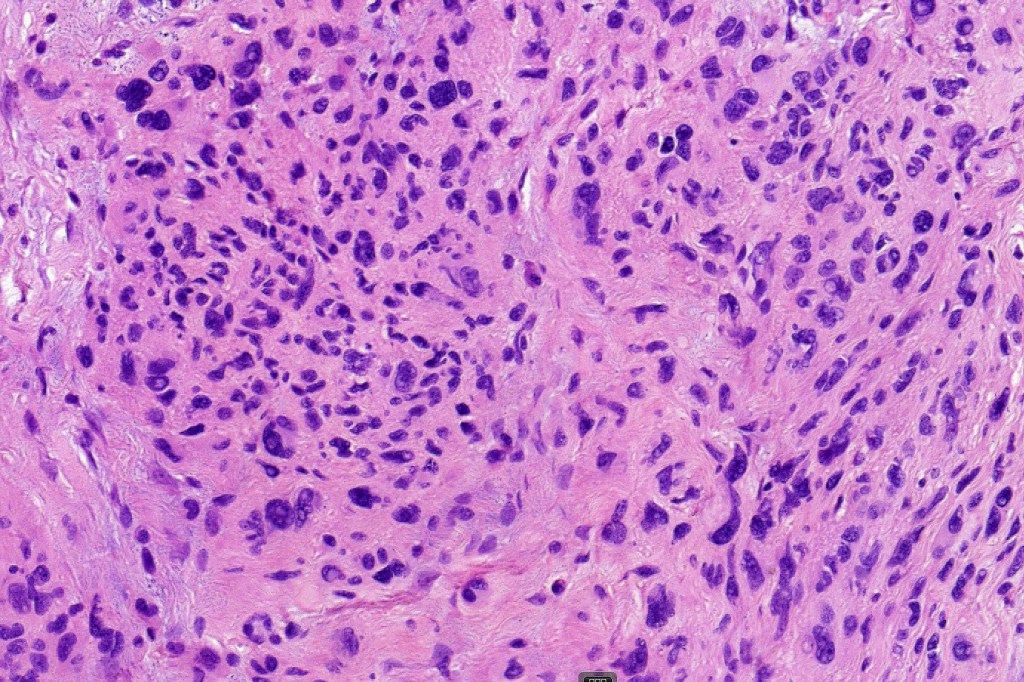

This is a rare variant of melanocytic nevus, so-named because it shares some of the features of ancient schwannoma and not because of its age! It most often arises on the face of older patients as a flesh colored or erthematous nodule. Its importance is that it may be mistaken as melanoma by the unwary.
Histological features
•Dome shaped silhouette
•Mixed cell population- pleomorphic cells (nevoid or Spitzoid)with vesicular or more often intensely hyperchromatic nuclei & often prominent nucleoli, admixed with banal nevus cells, intranuclear cytoplasmic pseudo-inclusions
•Very occasional mitoses may be found
•Sclerosis with hyalinization
•Vascular ectasia sometimes with thrombosis & hemorrhage
•Myxoid change
•Cystic change

Leave a comment